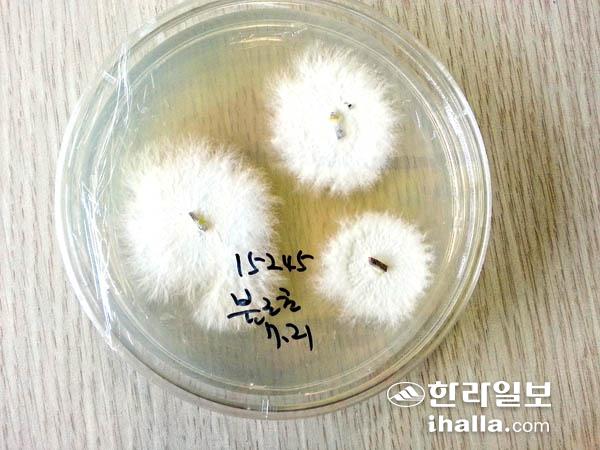

버섯 가죽을 이용해 만든 가방(출처:에르메스).
버섯균사체 이용해 만든 인조가죽으로 가방·신발 등 제품 탄생포장재 스티로폼도 버섯균사로 제작… 사용 후 퇴비 활용 친환경식물성 고기로 비건족 사로잡아… 우리나라도 관련 연구 활발
어떤 버섯이 어떻게 쓰일지는 아무도 모른다. 미래의 무한한 가치를 지니고 있다는 것만 안다. 쓰임새는 모르지만 나는 지난 10여년 간 꾸준히 버섯을 채집하고 종균을 키워 보관한다. 내가 아니더라도 누군가의 연구를 통해 제주의 버섯이 우리나라 산업 전반에 큰 이익을 가져오리라 믿으면서….
▶버섯의 모체인 균사체를 이용해서 인공 가죽을 만들 수 있다=동물 가죽만 고집하던 가방 명품 '에르메스'에서는 버섯균사체 소재의 가죽을 만드는 스타트업 회사인 '마이코 윅스'와 협업해서 버섯 균사체를 이용한 인공 가죽을 개발해 클래식 '빅토리아 백'으로 선보였다.

비건 슈즈(출처:아디다스).
'실바니아(Sylvania)'라고 이름 붙여진 이 인공 가죽은 버섯의 균사체를 가죽처럼 가공하는 '파인 마이셀리움(Fine Mycelium)'으로 명명된 특허 기술로 탄생했다. 균사체를 압축해서 만든 가죽은 동물의 가죽만큼 내구성이 우수하고 무두질이 필요 없어서 폐수도 덜 발생한다. 또 동물과 달리 균사체는 몇 주 정도만 키우면 가죽을 만들 수 있어 경제적이며 땅에 묻으면 쉽게 썩어 분해되는 장점이 있다.
동물 가죽은 목축으로 인한 환경·에너지·수자원 관련 이슈가 있고, 기존의 인조가죽은 제조과정에 들어가는 독성 화학공정 및 분해되지 않는다는 문제점이 있는 반면, 균사체 기반 가죽은 이런 문제점을 극복할 수 있는 계기가 될 수 있다.
▶비건 슈즈, 지속 가능한 의류=전 세계 바다에 존재하는 플라스틱 쓰레기의 양은 1억5000만t에 이른다고 한다.

버섯을 이용해 만든 '머쉬룸 가죽'.
거기에 매년 새로운 쓰레기가 800만t씩 버려진다고 하니 보통 심각한 문제가 아니다.
아디다스가 최근에는 바이오테크 스타트업인 '볼츠 쓰레즈(Bolts Threads)'와 협약해 버섯 균사체를 활용한 식물성 가죽 마일로(Mylo)로 만든 최초의 비건 슈즈인 '스탠 스미스 마일로'를 공개했다. 재생 가능한 균사체로 만든 가죽으로 플라스틱 폐기물을 없애기 위한 노력의 일환이다. 이는 세계에서 가장 오염이 심한 분야 중 하나인 패션 산업의 탄소발자국을 줄이는 데 중요하다.
▶스티로폼도 만들 수 있다고?=우리가 쓰고 있는 스티로폼은 활용도가 다양하고 사용할 곳도 다양하지만 부피가 크고 재활용이 안 된다는 단점이 있다. 곰팡이로 포장재를 만드는 기술은 에코베이티브 디자인에서 개발한 것으로 버섯의 균사가 스스로 밀도가 높은 섬유조직을 만든다는 사실에서 착안해 포장 틀 속에 영지버섯(ganoderma)의 균사체와 함께 영양분이 될 톱밥을 넣어준다. 그리고 5~7일 정도 숙성시키면 균사체가 빈 공간을 채워

균사체가 가죽으로 변신하는 말굽버섯.
고분자 물질을 형성하며 포장재가 완성된다. 스티로폼처럼 가볍고 내구성도 튼튼하며 사용하고 난 뒤에도 퇴비로 활용할 수 있다.
스웨덴 가구 대기업 IKEA와 컴퓨터 제조업체인 Dell은 이미 균사체 기반 포장을 사용하기로 약속한 가장 큰 기업 중 일부이며, 영국의 무 알코올 주류 제조업체인 Seedlip과 같은 소규모 회사도 이러한 추세에 합류했다.
현재 에코베이티브에서는 매년 400t 이상의 포장재와 가구를 만들어 내고 있는데 컴퓨터 회사인 Dell에서도 매년 이 포장재를 50만 개씩 사용하고 있으며 미국 해양대기청은 쓰나미 감지 장치를 띄우는 데 필요한 부표를 균사 소재 부품으로 대체하고 있다.
▶동물이 없는 육류 배양육&발효육=균사체는 식물성 '고기'를 만드는데도 사용할 수 있다. 버거나 다진 고기와 같이 주로 분쇄 형태로 나오는 다른 육류 대체품과 달리 균사체는 3D형태 또는 모양의 후 처리로 성장할 수 있다. 콜로라도에 기반을 둔 대체 고기 브랜드인 Meati는 균사체 기반 제품이 결국 산업적으로 생산된 동물 고기보다 99% 적은 물과 땅을 사용하고 99% 적은 탄소를 배출할 것이라고 주장한다. 동물에 비해 99% 적은 탄소를 배출하는 것을 목표로 한다.

느타리버섯은 고기로 변신이 가능하다.
비건족이 증가하면서 앞으로 인공육 시장이 빠르게 성장할 것이다. 아직은 인공육 시장에서 독보적인 기업이 출현하지 않은 만큼 기회는 더 많다. 마시멜로처럼 부드럽게 성장한 균사체는 스팸, 베이컨 등으로 가공돼 식료품 코너를 채우고 있다.(출처: Meati)
▶우리나라도 균사체를 활용한 연구가 시작되다=우리나라에서 버섯균사체를 이용한 연구의 선두주자는 '마이셀'이다. 마이셀프로젝트 사성진 대표는 버섯을 이용해 대체 고기를 만들고 대체 가죽을 만드는 연구를 하고 있다.

불로초(영지) 균사체는 스티로폼이 된다.
불로초(영지) 균사체.
버섯 균사체를 소재로 인조가죽을 생산하는 기술은 범용기술로 인정받는다. 우리나라에서 자라는 영지버섯, 상황버섯과 같은 균사체를 사용하면 특허의 범위에 영향을 받지 않는다. 사업 성공의 관건은 '어떻게 버섯 균사체를 빠르게 원하는 면적으로 키우는가'인데 이는 생산 노하우에 해당한다. 마이셀은 균사체를 원료로 한 가죽 제품을 본격적으로 생산을 시작해 늦어도 2021년 말까지는 대량 생산 체제를 구축하고 2022년 2분기쯤 자동차 시트용으로 가죽을 공급하는 것을 목표로 하고 있다.
▶화장품, 의약품 생산, 환경오염 저감=균사체를 키우고 남은 배양액도 유용하다. 여기에는 체외 다당체인 베타글루칸 등 발효물질이 들어 있어 화장품이나 의약품 원료로 활용할 수 있다. 마이셀은 2021년 균사체 배양액을 활용한 화장품을 생산해 시장에 내놓을 계획이다.
공장식 축산의 부정적인 결과로 조류독감 등 비상사태가 주기적으로 일어나고 그때마다 정부와 지자체는 살처분으로 대처한다. 살처분은 이후의 환경적 비용도 어마어마하고 사체가 부패하면서 박테리아 번식이 증폭해 여름에는 문제가 심각하다. 이때 균사체를 활용해서 동물 사체를 미생물적으로 분해하고 최대한 일찍 자연으로 돌아가도록 환경오염을 저감 시킬 수 있다.(출처:EARTH TECH)
<고평열 자원생물연구센터 대표 농학박사>